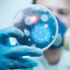
S.Arabistan'da corona virüsü alarmı

MORE IN DÜNYA»
resimsiz















Galatasaray'ın Avrupa kupalarındaki 278. sınavı
13 Şubat 2019 10:06
ABD'de ahırda kilitli 4 çocuk bulundu
13 Şubat 2019 09:48
İsrail ve Birleşik Arap Emirlikleri arasındaki gizli görüşmeler …
13 Şubat 2019 09:48 resimsizUyuşturucu satıcısı çift tutuklandı
13 Şubat 2019 08:59 resimsizOzan Arif kimdir? İşte ünlü ismin hayatı…
13 Şubat 2019 08:59 resimsizİçeriden aldığı bilgileri 7 akrabasına dağıttı
13 Şubat 2019 08:59 resimsiziPad mini 5 nasıl olacak?
13 Şubat 2019 08:59
Kamyonetin altında 700 metre sürüklenen kadın öldü
13 Şubat 2019 08:59 resimsizRuslar Fenerbahçe - Zenit maçının skorunu bildi
13 Şubat 2019 08:59 resimsizFenerbahçe'nin hayal kırıklığı
13 Şubat 2019 08:59 resimsizBankaların emekli maaşı promosyonu 450 TL'ye kadar çıktı
13 Şubat 2019 08:59
Çinli teknoloji devi Huawei'den Yeni Zelanda'ya reklamlı çağrı
13 Şubat 2019 08:51
Fransa'da köpek havlamasına para cezası
13 Şubat 2019 08:46
NATO Türkiye-Rusya ilişkisinden endişeli
13 Şubat 2019 07:51
Fransa'da bin 796 sarı yelekliye hapis cezası
13 Şubat 2019 07:51
ABD ambargonun meyvelerini topluyor
13 Şubat 2019 07:51
Yahudi yerleşimciler Filistinlilerin evlerine saldırdı
13 Şubat 2019 07:47
Yurt Dışı Türkler ve Akraba Topluluklar Başkanı Eren: Hedefimiz …
13 Şubat 2019 07:47
Maduro: ABD yönetimi Ku Klux Klan gibi bir çete
13 Şubat 2019 06:46
S.Arabistan'da corona virüsü alarmı
13 Şubat 2019 05:46
İtalyanlar süt dökerek protesto gerçekleştirdi
13 Şubat 2019 02:46
Duterte ülkesinin ismini değiştirebilir
13 Şubat 2019 00:50
Soros Avrupa Birliği'ni uyardı
13 Şubat 2019 00:45HOTTEST NEWS IN DÜNYA»
WHAT'S NEW IN DÜNYA»
- Eyvah eyvah durum bu sefer ciddi! Dev astero…
- NATO Genel Sekreteri Stoltenberg'den Rusya'y…
- İran Cumhurbaşkanı Reisi ile Rusya Devlet Ba…
- Rusya kendini yalanladı! Uzay aracı nasıl dü…
- Fransa'yı etkisi altına alan akım: Daltonlar
- Avrupa'da gaz fiyatları yükselişe geçti! Alm…
- Azerbaycan: Ermenistan'la gerginlik sürüyor
- Jens Stoltenberg: Rusya'nın uydu vurması per…
- Kardeş ülke harekete geçti: Düşmanın saldırı…
- İsrail güçleri tarafından vurulan Filistinli…
- Facebook’ta tanıştığı ABD’li gençle, Zoom’da…
- Polonya-Belarus sınırında gerilim: Tazyikli …
- Koronavirüs hapında flaş gelişme! Pfizer lis…
- Konut fiyatlarında ilk gerçekleşti
- Dolar: TL'nin bugünkü değer kaybını ekonomis…
- Sıfır otomobilde fiyat oyunu
- İş Bankası Genel Müdürü'nden Erdoğan'ı kız…
- Atilla Yeşilada İktidarı 90’lı yıllardan ve…
- Getir ünlü alışveriş sitesine ortak oluyor.…
- Kuzey Kore lideri Kim Jong'dan akılalmaz pro…


